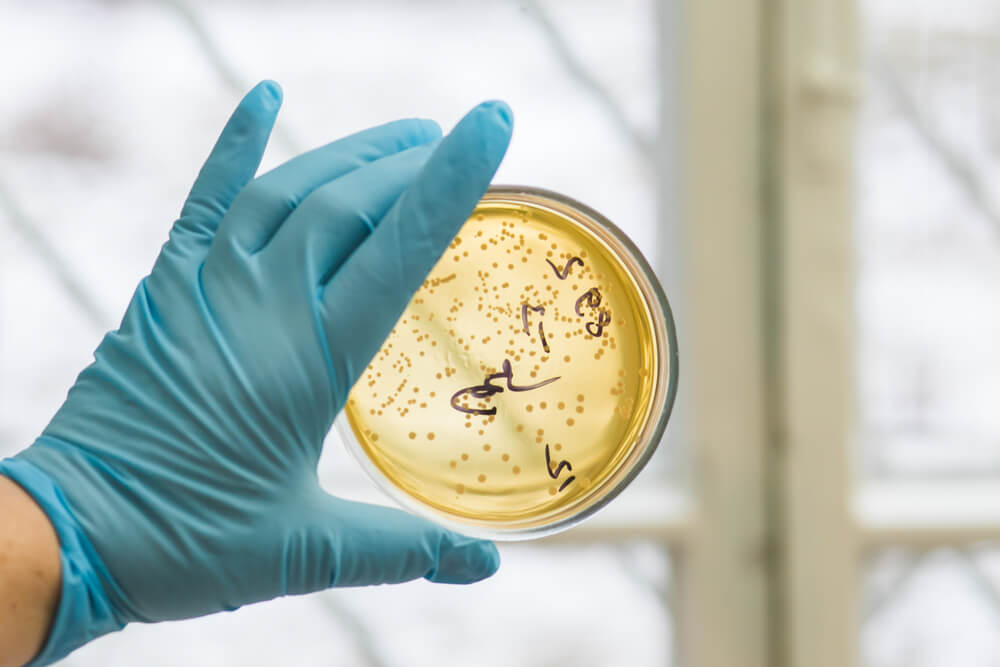

Женщина из Висконсина поцарапалась и заразилась страшной болезнью: ей ампутировали все пальцы и ногу
Мать троих сыновей Алесия Кеннен из Райс-Лейк (Висконсин) уже не первый год борется с ужасной болезнью – стрептококком. Причиной заражения стала случайная царапина, которую она получила, неудачно упав на ковер. Об этом пишет Fox9.
Фото: Depositphotos
Через некоторое время после получения царапины женщина начала сильно болеть. В июне 2015 года инстинкты подсказали ей, что острая боль под правой подмышкой была серьезной, и она тут же обратилась в больницу.
«Медсестра и доктор сразу поняли, что что-то не так», — сказала Кеннен.
Через несколько дней у Кеннен началось внутреннее кровотечение. Ее легкие наполнились жидкостью, жизненно важные органы начали отказывать, а конечности почернели.
Врачи сказали ее семье попрощаться с женщиной.
По теме: Сколько стоит не умереть в Америке
«Они сказали моей семье, что не знают, что со мной, и настало время попрощаться», — вспоминает Кеннен.
Но когда один из ее сыновей начал жаловаться на боль в горле, врачи наконец поняли, что им нужно делать.
«Тогда они проверили всех троих сыновей на стрептококковое воспаление горла (одна из разновидностей инфекционного фарингита), и у всех был положительный результат», — сказала она.

Фото: gofundme.com
У Кеннен был диагностирован синдром стрептококкового токсического шока.
Это те же самые бактерии, которыми заразились ее дети. Они проникла в кровь женщины через небольшую царапину от ковра на ее плече.
«Всего спустя неделю маленькая царапина от ковра чуть не стоила мне жизни», — сказала Кеннен.
19 июня 2015 года легкие Алесии отказали. Она нуждалась в переливании крови из-за внутреннего кровотечения, ей также был необходим диализ. Инфекция продолжала распространяться. Затем ей пришлось ампутировать фаланги пальцев на руках.
Наконец, 7 августа 2015 года Кеннен признали достаточно здоровой, чтобы она могла отправиться домой.
Алексия продолжала бороться с инфекцией, и 30 января 2016 года ей пришлось ампутировать пальцы на обеих ногах.
Доктор Стейсен Марушек из Медицинского центра округа Хеннепин (Миннесота) говорит, что болезнь может распространяться очень быстро, хотя и встречается довольно редко.
Врачи говорят, что эта инфекция была у большинства людей в тот или иной момент, но в очень редких случаях она приводит к таким последствиям.
По теме: Американские ученые обнаружили новый природный антибиотик
«У каждого человека есть стафилококк и стрептококк, живущие на их коже, и если есть ранение, можно очень легко заразиться и получить токсический шок. Но если повезет, иммунная система справится с бактерией», — сказал Марушек
Хотя на сегодняшний день у Кеннен нет инфекции, последствия токсического шока будут с ней навсегда.
«Я не могу поверить, как я прошла через все это», — сказала она.
Все пальцы ее рук и ног уже были ампутированы ранее, а правую ногу ниже колена пришлось ампутировать в 2019 году, когда болезнь снова начала прогрессировать.
Она надеется, что это редкое заболевание больше не причинит ей вреда. Докторр Марушек говорит, что на самом деле нет надежного способа предотвратить приступ токсического шока, но немедленное промывание всех порезов и царапин мылом и водой может помочь.
Читайте также на ForumDaily:
Американские ученые обнаружили новый природный антибиотик
Сколько стоит не умереть в Америке
Плотоядные бактерии: как избежать самой страшной угрозы для здоровья на пляже
Подписывайтесь на ForumDaily в Google NewsХотите больше важных и интересных новостей о жизни в США и иммиграции в Америку? — Поддержите нас донатом! А еще подписывайтесь на нашу страницу в Facebook. Выбирайте опцию «Приоритет в показе» — и читайте нас первыми. Кроме того, не забудьте оформить подписку на наш канал в Telegram и в Instagram— там много интересного. И присоединяйтесь к тысячам читателей ForumDaily New York — там вас ждет масса интересной и позитивной информации о жизни в мегаполисе.
















